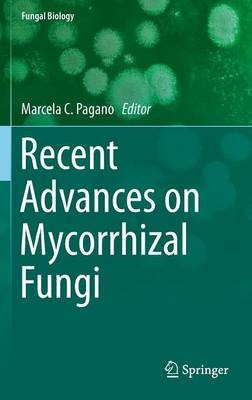
ibs

L’articolo è stato aggiunto alla lista dei desideri
IBS.it, l'altro eCommerce
Recent Advances on Mycorrhizal Fungi
Cliccando su “Conferma” dichiari che il contenuto da te inserito è conforme alle Condizioni Generali d’Uso del Sito ed alle Linee Guida sui Contenuti Vietati. Puoi rileggere e modificare e successivamente confermare il tuo contenuto. Tra poche ore lo troverai online (in caso contrario verifica la conformità del contenuto alle policy del Sito).
Grazie per la tua recensione!
Tra poche ore la vedrai online (in caso contrario verifica la conformità del testo alle nostre linee guida). Dopo la pubblicazione per te +4 punti
Altre offerte vendute e spedite dai nostri venditori

Tutti i formati ed edizioni
Promo attive (1)
Recent Advances on Mycorrhizal Fungi integrates work done by pre-eminent scientists, academics, and researchers dedicated to the study of mycorrhizas in laboratories around the world. The main aim of this book is to compile the information related to mycorrhizas advancement and their applications. First, an overview of the recent advances in mycorrhizal fungi is fully examined. Then, researchers from different countries address issues related to semiarid, xeric, and agro-ecosystems. A greater understanding of the ecology of this type of fungi will underpin efforts to provide new strategies for agriculture production systems and environmental solutions. Finally, relevant topics such as plant stress and ecological succession with regard to mycorrhizal symbioses are discussed. This book will be useful to those who work with mycorrhizas and important for academic and research teams, as well as to teachers, students, professionals and farmers. This information will be a key foundation to decision-makers worldwide and also for conservationists and ecologists.?
L'articolo è stato aggiunto al carrello
Le schede prodotto sono aggiornate in conformità al Regolamento UE 988/2023. Laddove ci fossero taluni dati non disponibili per ragioni indipendenti da IBS, vi informiamo che stiamo compiendo ogni ragionevole sforzo per inserirli. Vi invitiamo a controllare periodicamente il sito www.ibs.it per eventuali novità e aggiornamenti.
Per le vendite di prodotti da terze parti, ciascun venditore si assume la piena e diretta responsabilità per la commercializzazione del prodotto e per la sua conformità al Regolamento UE 988/2023, nonché alle normative nazionali ed europee vigenti.
Per informazioni sulla sicurezza dei prodotti, contattare productsafetyibs@feltrinelli.it
L’articolo è stato aggiunto alla lista dei desideri


